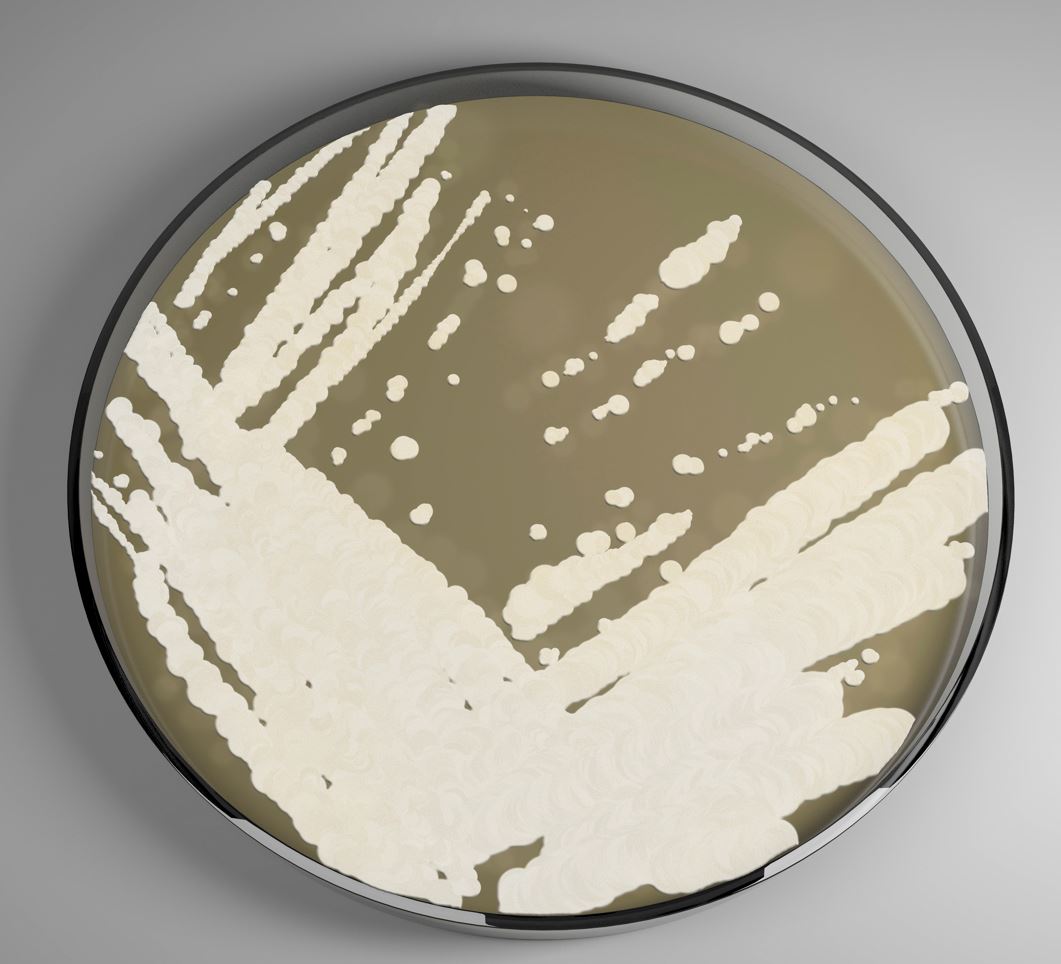

Seit Corona wissen ALLE, wie schnell sich plötzlich das gesamte Leben ändern kann. Müssen wir jetzt Angst vor einem Pilz-Erreger haben, der sich auch hierzulande ausbreitet?
CANDIDA AURIS
Experten sind besorgt, denn der Hefepilz breitet sich laut einer Studie auch in Deutschland aus. Diese ist zwar im Vergleich zu Ländern wie den USA noch gering, aber Forscher schlagen Alarm.
„Unsere Erfahrung zeigt, dass jede Infektion mit Candida auris schwer zu behandeln und für Patienten und Patientinnen potenziell lebensbedrohlich ist“
So Dr. Alexander Aldejohann, Co-Autor der Studie im Deutschen Ärzteblatt.
TÖDLICH
Vor allem für immunschwache Menschen ist die Gefahr einer Infektion groß. Der Pilz-Erreger kann Blutvergiftungen und schwere Organschäden hervorrufen.
Besonders gefährlich: Gegen rund 80 Prozent der herkömmlichen Antibiotika zeigt sich Candida auris resistent.
Im ersten Schritt fordern Ärzte nun eine Meldepflicht in Deutschland.